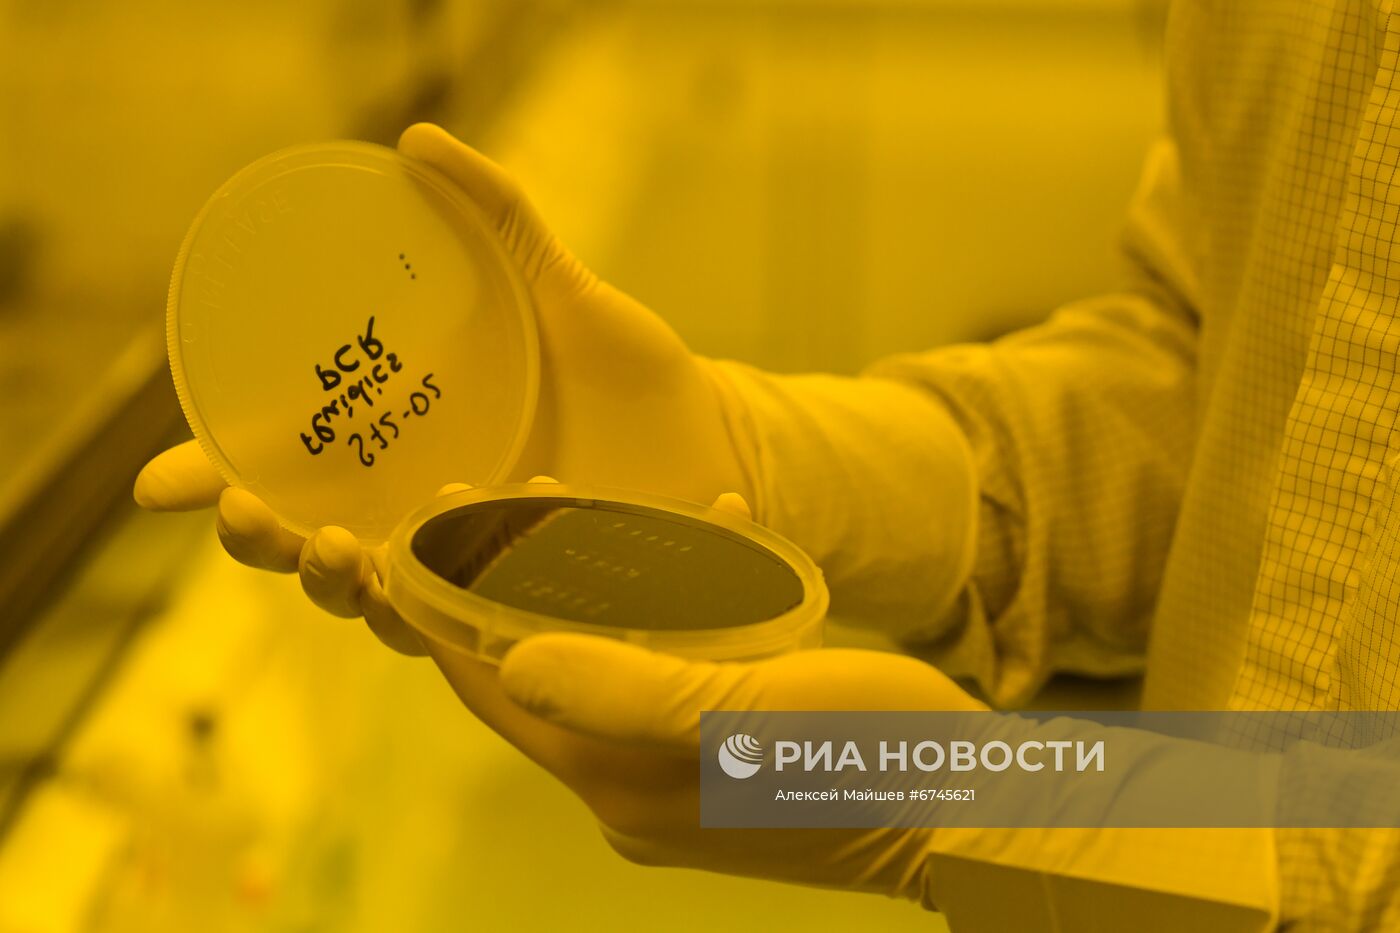
Создание микрофлюидных чипов в научном центре "Функциональные микро/наносистемы" МГТУ им. Н.Э. Баумана

Сотрудник научного центра "Функциональные микро/наносистемы" МГТУ им. Н.Э. Баумана демонстрирует пластину с микрофлюидными чипами для биологических экспериментов. Ученые и инженеры научно-образовательного центра "Функциональные Микро/Наносистемы" МГТУ им. Н. Э. Баумана и ФГУП ВНИИА им. Н. Л. Духова совместно с ИБХФ РАН разработали и экспериментально апробировали микрофлюидное устройство для автоматического разделения бактерий и вирусов в анализируемой пробе.
- Категории: Наука и технологии
- Место: Москва, Россия
- Дата события: 13.01.2022
- Дата поступления: 20.01.2022
- Автор: Алексей Майшев
- Кредит: РИА Новости
- Источник: РИА Новости
- Оригинал: Цифра
- Формат: JPEG, 5172x3448px, 9.4Mb
- Job-ID: feae69b49cef41a4